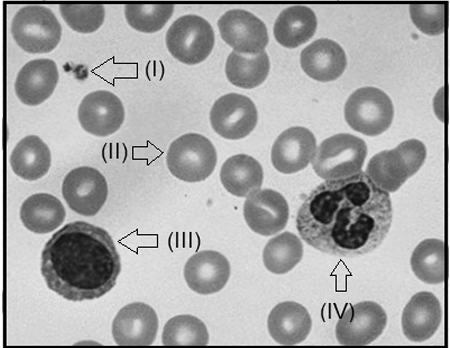
Enunciado 3165606-1

O hemograma é um exame que tem por finalidade avaliar as células sanguíneas da série, branca, vermelha e
plaquetas. A análise quantitativa dá-se por meio da contagem manual ou automatizada dessas células. A análise
morfológica, por sua vez, é a realizada através do exame microscópico do esfregaço sanguíneo, após coloração
específica. O conhecimento sobre as estruturas das células do sangue permite identificar os diversos elementos
figurados que compõe essa matriz biológica de grande utilização nas análises clínicas.
Fonte: ALVARENGA, Felipe Queiroz. Hematologia: distribuição celular no sangue periférico. 20 set. 2022.
Observe a figura a seguir de um esfregaço sanguíneo, realizado a partir de um sangue total colhido em EDTA, em lâmina de vidro e corado pelo panótico rápido para evidenciar os elementos figurados do sangue.
Figura: Células hematológicas em um esfregaço sanguíneo

Fonte: ESFREGAÇO SANGUÍNEO HEMOGRAMA. Disponível em www.google.com.br/imagem. Acesso em 19 set 2022.
A partir da análise do enunciado e da figura do esfregaço sanguíneo, é possível inferir que as estruturas representam os seguintes elementos figurados do sangue:
Fonte: ALVARENGA, Felipe Queiroz. Hematologia: distribuição celular no sangue periférico. 20 set. 2022.
Observe a figura a seguir de um esfregaço sanguíneo, realizado a partir de um sangue total colhido em EDTA, em lâmina de vidro e corado pelo panótico rápido para evidenciar os elementos figurados do sangue.
Figura: Células hematológicas em um esfregaço sanguíneo
Fonte: ESFREGAÇO SANGUÍNEO HEMOGRAMA. Disponível em www.google.com.br/imagem. Acesso em 19 set 2022.
A partir da análise do enunciado e da figura do esfregaço sanguíneo, é possível inferir que as estruturas representam os seguintes elementos figurados do sangue: